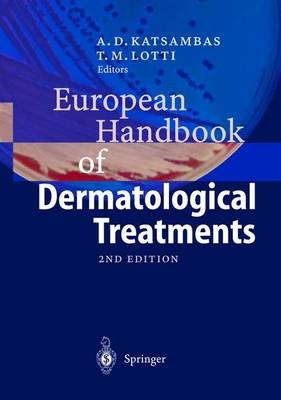
European Handbook of Dermatological Treatments -

European Handbook of Dermatological Treatments
Springer Berlin (Verlag)
978-3-540-00878-1 (ISBN)
- Titel erscheint in neuer Auflage
- Artikel merken
Diseases.- Acne. Acne Inversa. Actinic Keratosis. Adamantiades-Behcet's Disease. Alopecia Areata Management. Androgenic Alopecia. Antiphospholipid Syndrome. Aphthous Stomatitis. Apocrine Miliaria. Atopic Dermatitis. Balanitis. Based Cell Carcinoma. Bowen's Disease. Bullous Pemphigoid. Candidiasis (Candidosis-Moniliasis-Trush). Chronic Actinic Dermatitis. Cicatricial Alopecia. Contact Dermatitis. Cutaneous Vasculitis. Darier's Disease. Dermatitis Herpetiformis. Dermatomyositis. Dermatophyte Infections. Diaper Dermatitis. Drug-Induced Pemphigus. Drug Eruption. Drug Photoosensitivity. Eccrine Miliaria. Epdermolysis Bullosa. Erysipelas. Erythema Multiforme. Erythema Nodosum. Erythrasma. Erythroplasiia of Queyrat. Factitial Dermatitis. Folliculitis. Furuncles and Carbuncles. Gonorrhoea. Granuloma Annulare. Hand Dermatitis. Herpes Simplex Genitalis. Herpes Simplex Virus Infection (Oro-facial). Herpes Zoster. Hirsutism. HIV Infection and AIDS. Hyperhidrosis. Ichthyoses. Impetigo. Kaposi's Sarcoma. Keloids and Hypertrophic Scars. Keratoacanthoma. Leg Ulcers. Leishmaniasis. Lentigo Maligna. Leprosy of Hansen's Disease. Lichen Planus. Lichen Simplex Chronicus. Lupus Erythematosus. Lymphomas Primary Cutaneous. Malignant Melanoma. Mastocytosis (Urticaria Pigmentosa). Melasma. Mite Bites. Molluscum Contagiosum. Morphea: Circumscribed Scleroderma. Necrobiosis Lipoidica. Nevi (Benign Melanocytic).Nummular Eczema. Pediculosis. Pemphigus Erythematosus. Pemphigus Foliaceus. Pemphigus Vegetans. Pemphigus Vulgaris. Photoageing. Pityriasis Lichenoides Acuta. Pityriasis Lichenoides Chronica. Pityriasis Rosea. Pityriasis Rubra Pilaris. Polymorphic Light Eruption (PLE). Porphyrias. Pruritus. Psoriasis. Purpuras. Pyoderma Gangrenosum. Raynaud's Phenomenon. Rosacea. Sarcoidosis. Scabies. Seborrheic Dermatitis. Seborrheic Keratosis. Sjögren's Syndrome. Skin Diseases from the Marine Environment. Solar Urticaria. Squamous Cell Carcinoma. Subacute Cutaneous Lupus Erythematosus. Syphilis.Systemic Sclerosis - Scleroderma. Tick Dermatoses. Tinea Versicolor.Pityriasis Versicolor. Toxic Epidermal Necrolysis. Urethritis: Gonococcal. Urethritis: Nungonococcal. Urticaria. Varicella. Vascular Birthmarks: Vascular Malformations and Haemangiomas. Vitiligo. Warts and Condylomas. Xanthomas. Methods.- Biopsy. Chemical Peelings. Cryosurgery. Curettage. Electrosurgery. Epiluminescence Microscopy of Pigmented Skin Lesions. Extrracorporeal Photochemotherapy. Hair Restoration Surgery. Lasers in Dermatology. Moh's Surgery. Patch Testing. Photochemotherapy. Sclerothery. Skin Augmentation (Fillings). Skin Resurfacing with the CO2 Laser. UVB Phototherapy. Vaccine Strategies via Dendritic Cells in the Treatment of Malignant Melanoma. Drugs.- Antibacterial Agents in Dermatology. Antifungals. Antihistamines. Antiviral Drugs. Bleaching Agents. Corticosteroids Topical. Glucocorticoids Systemic. Insect Repellents. Psychoactive Agents in Dermatology. Retinoids. Scabicides and Pediculicides. Sunscreens. Topical Anaesthetics in Dermatology. Topical Preparation and Vehicles.
From the reviews of the second edition:
"The book is an updated edition of the first one which was well accepted by dermatologists and other medical professionals. ... To write such a compendium is a daring and ambitious enterprise. ... full credit has to be given to the Editors for their endeavor in preparing this excellent and extensive handbook. ... The Editors and coauthors succeeded in gathering a cornucopia of information, extremely useful to residents, practicing dermatologists, general practitioners and other specialists as well as to experienced teachers of dermatology." (Aleksej Kansky, Acta Dermatovenerologica, Vol. 13 (1), 2004)
| Sprache | englisch |
|---|---|
| Maße | 170 x 242 mm |
| Gewicht | 1445 g |
| Einbandart | gebunden |
| Themenwelt | Medizin / Pharmazie ► Medizinische Fachgebiete |
| Schlagworte | Dermatitis • Dermatological Drugs • Dermatologie; Handbuch/Lehrbuch • Dermatologie / Hautkrankheiten; Handbuch/Lehrbuch • Dermatology • Diagnosis • Differential Diagnosis • Erysipel • Herpes Simplex • Hyperhidrosis • Impetigo • Pruritus • Rosacea • Skin Disease • Treatments • urticaria |
| ISBN-10 | 3-540-00878-0 / 3540008780 |
| ISBN-13 | 978-3-540-00878-1 / 9783540008781 |
| Zustand | Neuware |
| Informationen gemäß Produktsicherheitsverordnung (GPSR) | |
| Haben Sie eine Frage zum Produkt? |
aus dem Bereich



